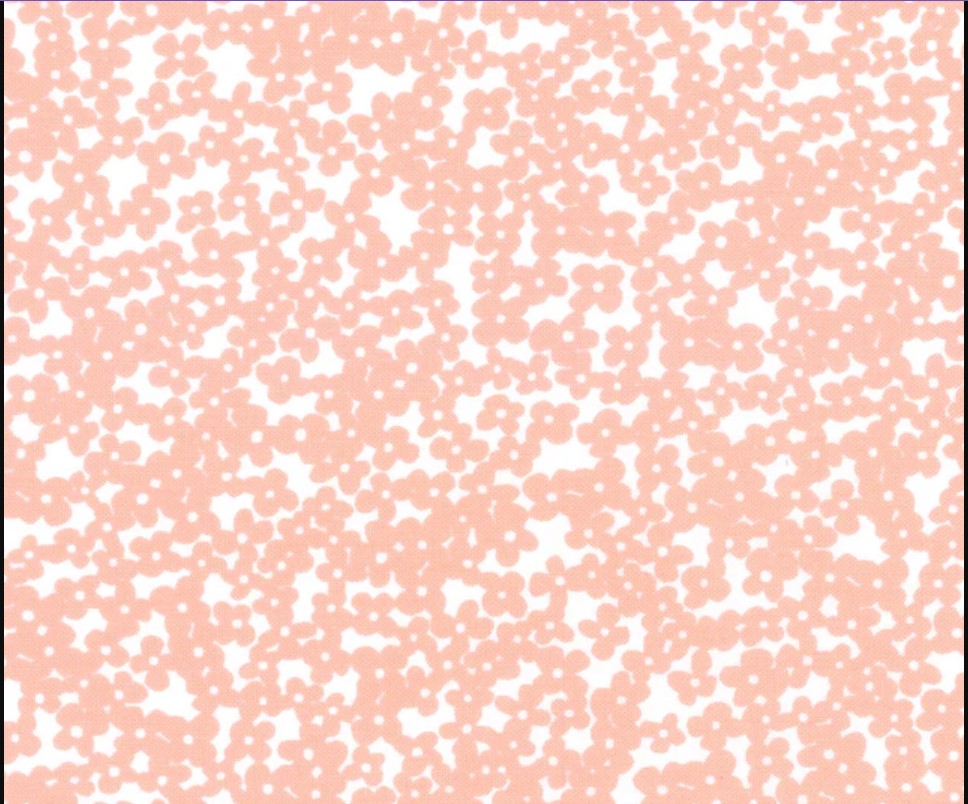

Juliette Tiny Floral Allover Light Coral Pink Angela Nickeas Wilmington Prints Cotton Fabric
Juliette Tiny Floral Allover Light Coral Pink Angela Nickeas Wilmington Prints Cotton Fabric
Couldn't load pickup availability
Additional Details
- Fabric Collection Juliette
- Brand Wilmington Prints
- Theme Floral
- Color Pink, White
- Width 42-45 inches
- Tags: Allover, Angela Nickeas, cotton fabric, Juliette, Light Coral, Pink, quilting, Tiny Floral, Wilmington Prints, WP-3064-29204-131,
Description
Juliette Tiny Floral Allover in Light Coral Pink by Angela Nickeas for Wilmington Prints 44 inches 100% Cotton Fabric WP-3064-29204-131
Width: 44 inches
Material: 100% cotton quilting fabric
Step into spring with the charming collection by designer Angela Nickeas. Juliette showcases a delightful array of fabrics adorned with delicate blooming florals, artfully paired with captivating geometric designs. Infused with light and airy hues, this collection embodies the essence of warmer weather, making it a perfect choice for the season.
This design is perfect for use in quilting projects, craft projects and even apparel.
Care: Machine Wash Cold / Easy Care
Multiple yards will be cut in a continuous piece.
Orders typically ship next business day.